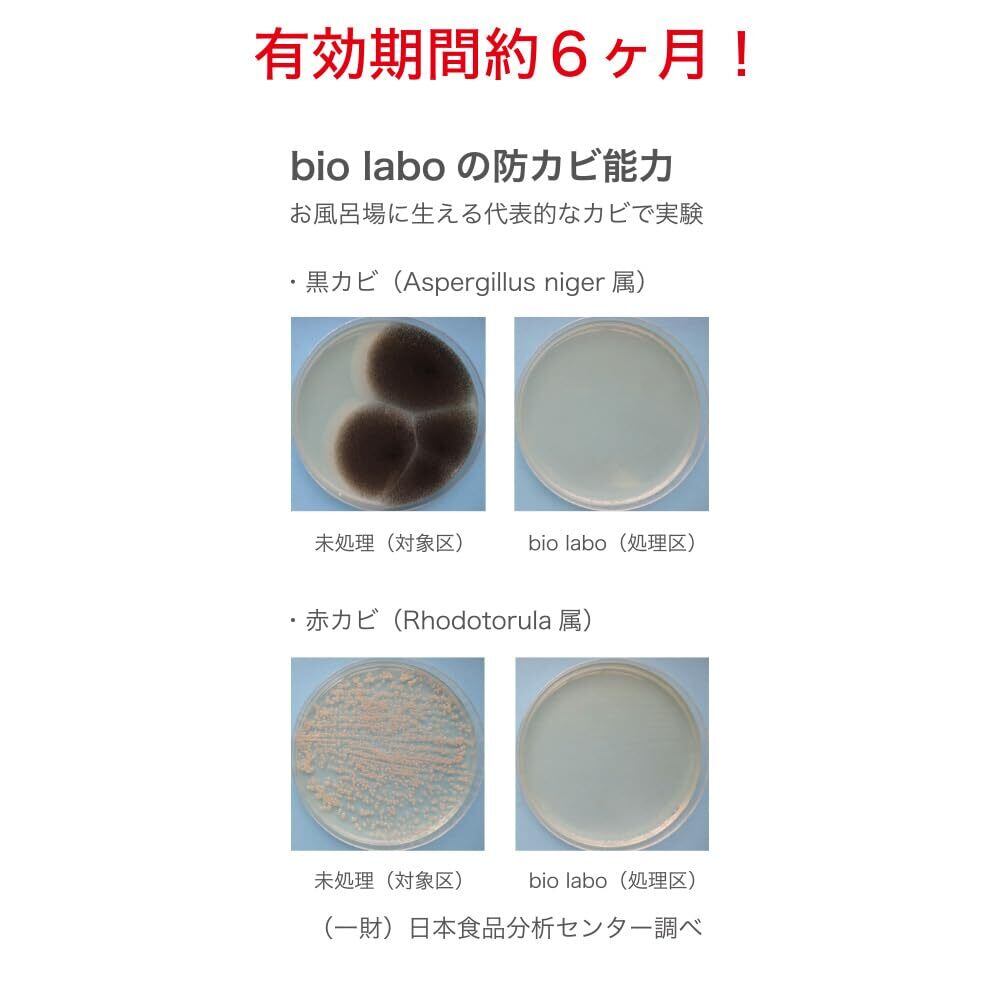

1/5
【新着商品】バイオラボ ウォールケースバス ホワイト (x2個) アトリエボーテ 期限管理シール セット 浴室 掃除 消臭 風呂掃除
¥3,060
残り1点
International shipping available
【商品名】
バイオラボ ウォールケースバス ホワイト (x2個) アトリエボーテ 期限管理シール セット 浴室 掃除 消臭 風呂掃除
【商品説明】
商品 ワンダム バイオラボ ウォールケースバス ホワイト
お風呂に貼るだけの簡単設置。
目立たないので気にならない。
ケースをはる箇所の汚れをきれいに取ります。ケース本体裏面のシール保護紙を剥がし、ケース本体の中心を押さえるようにして貼り付けてください。付属のステッカーに、貼った日付を油性ペンなどで記入し、本体に貼り付けて交換時期の目安にしてください。
本来の用途以外でのご使用はお避け下さい。アイコンが示すお風呂や水回りでご使用ください。
ブランド Generic
色 ホワイト
テーマ バス
パターン 無地
ユニット数 2 個
-
レビュー
(0)
最近チェックした商品
同じカテゴリの商品
その他の商品